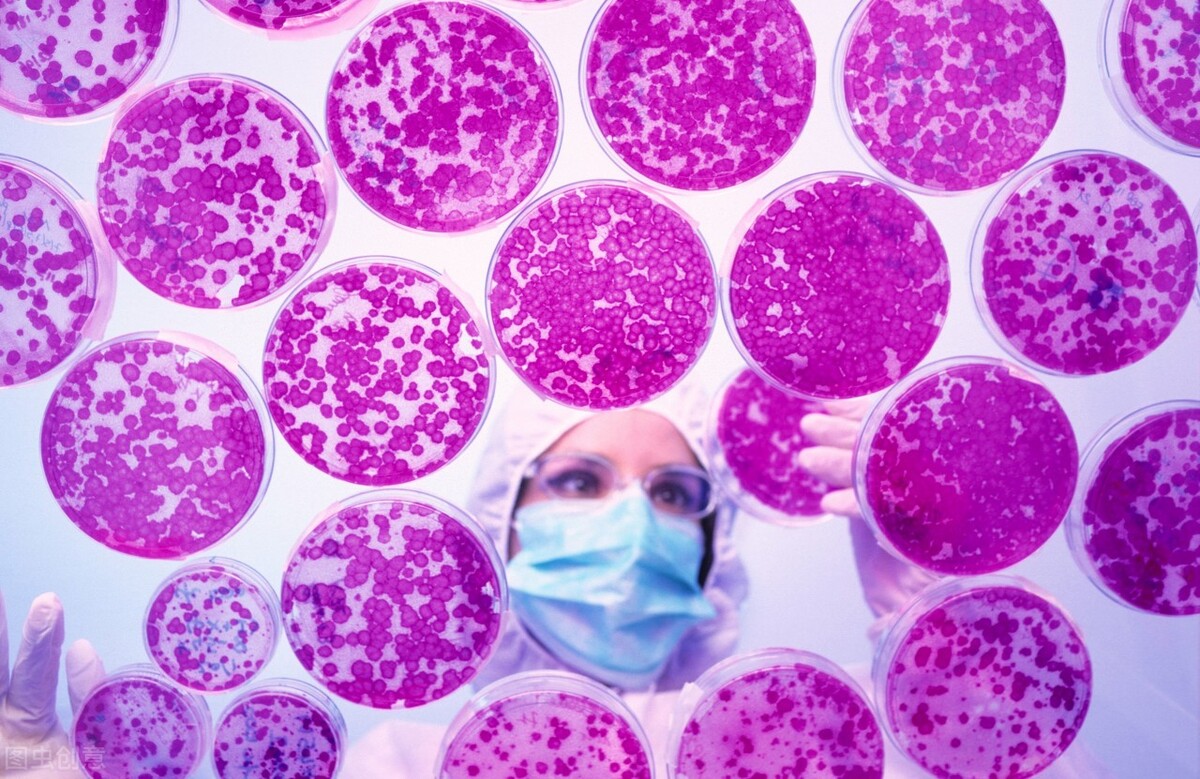
医学奇迹都是人类创造,医学奇迹干细胞

今天,又是好好学习的一天[奸笑]
人类历史上科学发展的每一步,都离不开动物实验的支持。
一定要做动物实验吗?
这个问题的答案直白到有些残忍——在人类现有的技术水平层面,是的,一定要这样做。

从基础科学,到药品检验,再到疫苗研发,都是动物们在替人类探索生命之路。
反过来,我们为什么要做动物实验?
这个问题的答案也简单到容不下丝毫的掩饰——为了人类自己能够拥有更高质量的生活和更长时间的寿命。
例如糖尿病的病理机制——胰腺功能缺失引起的糖尿病,最初也是通过对动物的观察或者利用动物的实验中得出来的。

几千年来,人类与糖尿病的斗争从未停歇过
如果小白鼠实验结果能在人类身上成功复制,一种能够将人类干细胞转化为胰岛素生产细胞的技术或将为糖尿病治疗带来巨大希望。
这还得从2020年那场轰动医学界的“糖尿病”事件说起。
时间转回2020年2月24日,国际知名期刊《Science》发表了一篇论文,内容是美国圣路易斯华盛顿大学医学院的科学家首次利用转化的人体多能干细胞产生胰岛素,在短短两周时间内就治愈了罹患重症糖尿病的实验小鼠,目前小鼠血糖水平连续9个月保持在正常水平。

“这些小鼠患有非常严重的糖尿病,每分升血液中的血糖读数超过500mg——这对人来可能是致命的。当我们给小鼠提供分泌胰岛素的细胞时,在两周内,它们的血糖水平已经恢复正常,并在许多个月内保持这种状态。”华盛顿大学的生物医学工程师杰弗里·米尔曼对此解释道。
该实验的降糖逻辑是,通过“欺骗”人类多能干细胞成为胰腺β细胞,以制造更多的胰岛素。而胰岛素能够促进蛋白质、脂肪和糖原的合成,抑制其分解,进而维持血糖动态平衡。
不得不说,多能干细胞又趁机火了一把。

在此之前,“多能干细胞治疗糖尿病”基本处于空窗期,甚至因为质疑一度成为研究的“黑洞”。
多能干细胞,是人体中一类空白的、未分化的细胞,同时又是一类具有自我更新、自我复制能力的潜能细胞,即具有成长为其他种类细胞的能力。
如何利用这种潜力,设计出调整干细胞的方法,使其成为糖尿病患者缺乏的胰岛素分泌细胞,进而达到控制高血糖并保持健康的目的,是科学家们这些年来一直研究的方向和核心。
而随着对干细胞操纵过程的了解加深,科学家们在动物模型中取得了渐进的成功。

视角给到米尔曼的实验室
其实早在2016年,他们就设计出了一种方法来生产分泌胰岛素的细胞——来自1型糖尿病患者——能对葡萄糖产生反应。
随后,他们攻克了如何提*干高**细胞衍生的胰腺β细胞的胰岛素分泌水平的难题。
而在最近的工作中,他们又解决新的挑战:减少这些过程中产生的“非目标”细胞的数量。
米尔曼表示:“当你试图将人类干细胞转化为产生胰岛素的β细胞,或神经元或心脏细胞时,一个常见的问题是——也会产生你不想要的其他细胞。在β细胞的情况下,我们可能会得到其他类型的胰腺细胞或肝细胞。”
尽管这些“非目标”细胞并无害处,但它们在控制血糖方面上如同“废物”,还会限制干细胞治疗的补救作用。
一直到2020年,该研究团队发现驱动干细胞成为胰腺细胞的转录因子与细胞的细胞骨架状态有关,细胞骨架是细胞内的支撑结构,由各种蛋白质纤维的微丝组成。这些蛋白质被称为肌动蛋白,在细胞功能中发挥着重要作用。
“操纵细胞——生物材料的相互作用和肌动蛋白细胞骨架的状态,改变了内分泌转录因子的表达时间和胰腺祖细胞分化为干细胞衍生的β细胞的能力。”研究人员解释道。
换句话说,我们可以通过控制肌动蛋白细胞骨架,更有效地确保胰岛素生成细胞的产生。如果该团队的小白鼠模型有任何意义,那么这种能力无疑会预示着干细胞治疗的未来。
“我们能够制造出更多的β细胞,这些细胞在小鼠体内的功能更好,其中一些小鼠在一年多的时间里一直处于治愈状态;而没有得到细胞移植的对照动物,诱发了更严重的程糖尿病,最终走向了死亡。”
这还不是全部。研究人员说,同样的细胞骨架操作也显示出更好地控制其他种类细胞分化的潜力,包括肝脏、食道、胃和肠道细胞。
如果是这样,该技术可能会加强干细胞对其他类型的病症的治疗,而不仅仅是糖尿病。

当然
“多能干细胞治疗糖尿病”的方案运用于临床来治愈人类,还有很长的路要走。
截止目前,该治疗方法还仅停留在动物试验的层次上,需进一步确保干细胞转化的安全性和精确性。
该论文的总结词是这样写的:“我们的研究整体上强调了细胞骨架动力学与可溶性生化因子协同工作,以调节内胚层细胞的命运,为改善分化结果开辟了新的机会。”这是该论文的总结词。
毋庸置疑的是,该研究正在为糖尿病治疗提供新的方向,它的重大突破,也或将为全球4亿罹患顽症的患者带来希望。
本文的第一句话是,人类历史上科学发展的每一步,都离不开动物实验的支持。
这里也想做一个补充:人类科学研究上的每一个突破,也必将承载人类走向更远的路。不仅仅是疾病。
你觉得,我们离能够用这种实验性的治疗方法来治愈人类,还有多长的距离?

了解更多